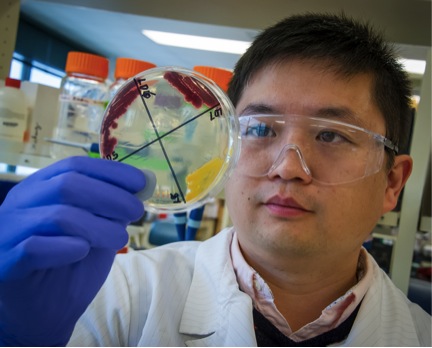
Xiaoliang Cheng

![]()  Karen Andrade Karen Andrade
Student Assistant
About Me Post-Northen Lab:
Research in Northen Lab:
|
![]()  Ozioma Anyanwu Ozioma Anyanwu
Student Assistant
About Me Post-Northen Lab:
University of Berkeley Undergraduate Student
Research in Northen Lab:
|
![]()  Zoila Aponte Zoila Aponte
Student Researcher
About Me Post-Northen Lab:
Microbiology PhD student at UC Berkeley Taga Lab
Research in Northen Lab:
Investigating microbial interactions and communities through grasses |
![]()  Richard Baran Richard Baran
Post-Doctoral Researcher
About Me Post-Northen Lab:
Thermo Fisher Scientific
Founder of Baran Biosciences
Research in Northen Lab:
Mapping microbial metabolism and metabolic interactions
|
![]()  Jenna T. Baughman Jenna T. Baughman
Student Assistant
About Me Post-Northen Lab:
Research in Northen Lab:
|
![]()  Sophie Berman Sophie Berman
Student Assistant
About Me Post-Northen Lab:
Research in Northen Lab:
|
![]()  Bailey Bonet Bailey Bonet
Affiliate
About Me Post-Northen Lab:
Assay Development Scientist at Perceive Biotherapeutics, Inc. |
![]()  Gabriella Boulton Gabriella Boulton
Student Assistant
About Me Post-Northen Lab:
Research in Northen Lab:
|
![]()  Sarah Brecht Sarah Brecht
Student Assistant
About Me Post-Northen Lab:
PhD Student at University of Zurich
|
![]()  Vanessa Brisson Vanessa Brisson
Research Affiliate
About Me Post-Northen Lab: Microbiology Research Scientist at Lawrence Livermore National Lab
Research in Northen Lab:
Researching the role of metabolites in the microbial communities of plants and algae
|
![]()  Erika Cagampan Erika Cagampan
Student Assistant
About Me Post-Northen Lab:
Research in Northen Lab:
|
![]()  Xiaoliang Cheng Xiaoliang Cheng
Post-Doctoral Researcher
About Me Research in Northen Lab:
High throughput metabolic and activity screening
|
![]()  Matthew Chu Matthew Chu
Student Assistant
LinkedIn Email |
![]()  Jason Cole Jason Cole
Student Assistant
About Me Post-Northen Lab:
Student at California State University, East Bay
|
![]()  Estelle Couradeau Estelle Couradeau
Post-Doctoral Researcher
About Me Post-Northen Lab:
Assistant Professor at Penn State University
Research in Northen Lab:
Soil physical structure matters!
|
![]()  Spencer Diamond Spencer Diamond
Research Affiliate
About Me Post-Northen Lab:
Principal Investigator at Innovative Genomics Institute at University of Berkeley
|
![]()  Yezhang Ding Yezhang Ding
Staff
About Me Post-Northen Lab:
Scientist at Joint Genome Institute
Research in Northen Lab:
Catecholamines-Plant Interactions
|
![]()  Megan Danielewicz Megan Danielewicz
Post-Doctoral Researcher
About Me Post-Northen Lab:
LCMS Scientist at Stanford University
Research in Northen Lab:
Metabolomics of Microbial Interactions
|
![]()  David Deng David Deng
Student Assistant
About Me Post-Northen Lab:
Software Engineer at Plaid
Research in Northen Lab:
Learning to use python for metabolite analysis
|
![]()  Tristan de Rond Tristan de Rond
Affiliate Graduate Student
About Me Post-Northen Lab:
Postdoctoral Fellow at Scripps Institution of Oceanography
Research in Northen Lab:
Expanding the scope of enzymatic reactions monitored using NIMS
|
![]()  Todd Duncombe Todd Duncombe
Post-Doctoral Researcher
About Me Post-Northen Lab:
Senior Innovation Engineer at Novo Nordisk
Research in Northen Lab:
Assay development at the interface of droplet microfluidics and mass spectrometry to streamline the discovery and optimization of biomanufacturing pathways.
|
![]()  Onur Erbilgin Onur Erbilgin
Post-Doctoral Researcher
About Me Post-Northen Lab:
Biological Data Scientist at Amyris, Inc.
Research in Northen Lab:
Microbial Community Dynamics
|
![]()  Oséias Rodrigues Feitosa Junior Oséias Rodrigues Feitosa Junior
Affiliate, Graduate Student Visitor
About Me Post-Northen Lab:
Postdoctoral Associate at Ludwig-Maximilians-Universität München
Research in Northen Lab:
Unveiling a plant-pathogen’s metabolome
|
![]()  Curt Fischer Curt Fischer
Affiliate
About Me Post-Northen Lab:
Head of the Metabolic Chemistry Analysis Center at Stanford University
|
![]()  Ellie Franklin Ellie Franklin
Student Assistant
About Me Post-Northen Lab:
Research in Northen Lab:
|
![]()  Jian Gao Jian Gao
Post-Doctoral Researcher
About Me Post-Northen Lab:
Postdoctoral Fellow at Berkeley Lab
Research in Northen Lab:
High Sensitivity Nanostructure-Initiator Mass Spectrometry (NIMS)
|
![]()  Kristen Geibel Kristen Geibel
Affiliate
About Me
Research in Northen Lab:
Development of fabricated ecosystems
I make custom fabricated ecosystems (EcoFABS) and set up and maintain live plants for experiments.
|
![]()  Amber Golini Amber Golini
Senior Research Associate
About Me Post-Northen Lab:
Project Manager, US Army Corps of Engineers
Research in Northen Lab:
|
![]()  Kshitiz Gupta Kshitiz Gupta
Research Affiliate
About Me Post-Northen Lab:
Research in Northen Lab:
|
![]()  Noel Ha Noel Ha
Post-Doctoral Researcher
About Me Research in Northen Lab:
High-throughput screening of metabolites and enzyme activity via microfluidics.
|
![]()  La Zhen Han La Zhen Han
Research Associate
About Me Post-Northen Lab:
Senior Research Associate at Pivot Bio
Research in Northen Lab:
Fabricated ecosystem development and sample processing
|
![]()  Daniel Hartono Daniel Hartono
Student Assistant
About Me Post-Northen Lab:
Research in Northen Lab:
|
![]()  Joshua Heinemann Joshua Heinemann
Post-Doctoral Researcher
About Me Post-Northen Lab:
Staff Scientist/Engineer at Montana Nanotechnology Facility at Montana State University-Bozeman
Research in Northen Lab:
Development of microfluidics based NIMS techniques to improve engineered organisms for biofuel and natural product synthesis
|
![]()  Yuntao Hu Yuntao Hu
Post-Doctoral Researcher
About Me Post-Northen Lab:
Data Scientist at PrognomiQ Inc
|
![]()  Zennan Hura Zennan Hura
Student Assistant
About Me Post-Northen Lab:
Research in Northen Lab:
|
![]()  Nicole Ing Nicole Ing
Post-Doctoral Researcher
About Me Research in Northen Lab:
Development of high-throughput enzyme assays to study enzymes involved in lignocellulosic breakdown.
|
![]()  Lauren Jabusch Lauren Jabusch
Post-Doctoral Researcher
About Me
Post-Northen Lab:
Business Development Specialist at Berkeley Lab
Research in Northen Lab:
How can plants thrive under stress?
|
![]()  Stefan Jenkins Stefan Jenkins
Staff
About Me Post-Northen Lab:
Director of Analytical Chemistry at Inscripta, Inc.
Research in Northen Lab:
Developing large-scale profiling applications to understand complex metabolic processes in cellular systems
|
![]()  Mia Jones Mia Jones
Student Assistant
About Me Post-Northen Lab:
Imperial College London, Bachelor’s degree program in biochemistry
|
![]()  Amy Johnson Amy Johnson
Research Associate
About Me Post-Northen Lab:
Research in Northen Lab:
|
![]()  Jacob Jordan Jacob Jordan
Post-Doctoral Researcher
About Me Post-Northen Lab:
ACS Analytical Graduate Research Fellow
|
![]()  Nicholas Justice Nicholas Justice
Affiliate
About Me Post-Northen Lab:
Research in Northen Lab:
|
![]()  Ashley Kang Ashley Kang
Affiliate
LinkedIn Email |
![]()  Ulas Karaoz Ulas Karaoz
Research Scientist
About Me
Post-Northen Lab:
Staff Computational Biologist Research Scientist at Berkeley Lab
Research in Northen Lab:
Understanding how microbiomes are structured and controlled using high-throughput sequencing and computational tools.
|
![]()  Manpreet Kaur Manpreet Kaur
Student Assistant
About Me Post-Northen Lab:
Research in Northen Lab:
|
![]()  Albina Khasanova Albina Khasanova
Affiliate Graduate Student
About Me Post-Northen Lab:
Research Assistant at The University of Texas at Austin
Research in Northen Lab:
Researching the impact of genetics and environment on plant roots and shoots.
|
![]()  Kenzo Khoo Kenzo Khoo
Student Assistant
About Me Post-Northen Lab:
Research in Northen Lab:
|
![]()  Nak Hyun Kim Nak Hyun Kim
Post-Doctoral Researcher
About Me Post-Northen Lab:
Korean Institute of Science and Technology (KIST)
Research in Northen Lab:
|
![]()  Janne van t Klooster Janne van t Klooster
Affiliate Graduate Student
About Me Post-Northen Lab:
|
![]()  Kristoffer Kordatos Kristoffer Kordatos
Affiliate Graduate Student
About Me Post-Northen Lab:
Research in Northen Lab:
|
![]()  Andrea Kuftin Andrea Kuftin
Senior Research Associate
About Me Post-Northen Lab:
Senior Research Associate at Sanofi
Research in Northen Lab:
As part of the Metabolomics group at JGI, we characterize the metabolite profile of organisms to gain insight and create linkages between sequence and function.
|
![]()  Cathelijne Lamboo Cathelijne Lamboo
Affiliate Graduate Student
About Me Post-Northen Lab:
Metabolic Disease Analyst at Amsterdam UMC
Research in Northen Lab:
Investigated bacterial growth through growth assays and exometabolomics
|
![]()  Rebecca Lau Rebecca Lau
Research Assistant
About Me Post-Northen Lab:
Scientist at Vividion Therapeutics
Research in Northen Lab:
Exchange of nutrients – the stability and health of soils.
|
![]()  Marion Leclerc Marion Leclerc
Affiliate
About Me Post-Northen Lab:
Research in Northen Lab:
|
![]()  Do Yup Lee Do Yup Lee
Postdoctoral Researcher
About Me Post-Northen Lab:
Professor at Seoul National University
Research in Northen Lab:
|
![]()  Hanneke Leegwater Hanneke Leegwater
Research Intern
About Me Post-Northen Lab:
PhD candidate at the Leiden Academic Centre for Drug Research
Research in Northen Lab:
Developing MAGI
|
![]()  Carolina Leguina Carolina Leguina
Affiliate Graduate Student
About Me Post-Northen Lab:
CONICET Scholarship in Pilot Plant for Microbiological Industrial Processes (PROIMI)
Research in Northen Lab:
Determining relationships between copper, quorum sensing, and the rhizosphere microbes
|
![]()  Kyle Lewald Kyle Lewald
Student Assistant
About Me Post-Northen Lab:
Probe Design Scientist at Advanced Cell Diagnostics
|
![]()  Johan Leveau Johan Leveau
Visiting Principle Investigator
About Me Post-Northen Lab:
Principle Investigator at Leaveau Lab
Research in Northen Lab:
Understanding plant health and disease from studying plant-microbe interactions at micrometer scales
|
![]()  Xiaomeng Liang Xiaomeng Liang
Postdoctoral Researcher
About Me Post-Northen Lab:
Staff Scientist at City of Hope
Research in Northen Lab:
|
![]()  Andrea Lubbe Andrea Lubbe
Postdoctoral Fellow
About Me Post-Northen Lab:
Senior Scientist at Brightseed
Research in Northen Lab:
Designing synthetic microbial consortia
|
![]()  Connie Ly Connie Ly
Administrative Support
About Me Post-Northen Lab:
Purchasing & Accounts Payable at REVA Medical, LLC. |
![]()  Maximino Manzanera Maximino Manzanera
Affiliate
About Me Post-Northen Lab:
University Professor at the University of Granada
Research in Northen Lab:
Visiting professor from the University of Granada in Spain studying plant growth promotion and microbial interactions.
|
![]()  Ritesh Mewalal Ritesh Mewalal
Post-Doctoral Researcher
About Me Post-Northen Lab:
Senior Scientific Engineering Associate at Berkeley Lab
Research in Northen Lab:
Investigating plant-microbe interactions to increase agricultural production
|
![]()  Anthony Meza Anthony Meza
Research Associate
About Me Post-Northen Lab:
QCD Operator at Chevron
Research in Northen Lab:
Investigating lipid metabolism in algae. LCMS based metabolomics of plants and soil systems.
|
![]()  Kate Miller Kate Miller
Affiliate
Email |
![]()  Annika Mosier Annika Mosier
Student Assistant
About Me Post-Northen Lab:
Research in Northen Lab:
|
![]()  Margarita Ros Munoz Margarita Ros Munoz
Affiliate, visiting researcher
Publications |
![]()  Clement Nicolle Clement Nicolle
Post-Doctoral Researcher
About Me Post-Northen Lab:
Research in Northen Lab:
Development of global metabolomics methods to analyze the contribution of microbial secondary metabolites in root exudation processes in the soil.
|
![]()  Jenny Onley Jenny Onley
Affiliate
About Me Post-Northen Lab:
Assistant Professor at Whitworth University
Research in Northen Lab:
|
![]()  Andrew Osborn Andrew Osborn
Postdoctoral Researcher
About Me Post-Northen Lab:
Natural Products Chemistry Scientist II at Hexagon Bio
Research in Northen Lab:
Genome mining of secondary metabolites
|
![]()  Manuel Porcar Manuel Porcar
Visiting scientist: University of Valencia
About Me Post-Northen Lab:
Lab leader at University of Valencia and CEO of Darwin Bioprospecting Excellence
Research in Northen Lab:
Microbiome metabolomics of solar panels in berkeley vs valencia
|
![]()  Wolfgang Reindl Wolfgang Reindl
Postdoctoral Researcher
About Me Post-Northen Lab:
Research in Northen Lab:
|
![]()  Nicholas Saicheck Nicholas Saicheck
Postdoctoral Scholar
About Me Post-Northen Lab:
Senior Manager BioA Development and Innovation at Labcorp Drug Development
Research in Northen Lab:
High-throughput approaches for investigation of microbial interactions within synthetic microbial communities
|
![]()  Jasmine Sanghera Jasmine Sanghera
Student Assistant
About Me Post-Northen Lab:
Research in Northen Lab:
|
![]()  Yasmeen Sawyer Yasmeen Sawyer
Administrative Support
LinkedIn Email |
![]()  Joelle Schlapfer Joelle Schlapfer
Post-Doctoral Researcher
About Me Post-Northen Lab:
SNF Prima Professor at University of Zurich
Research in Northen Lab:
Plants interactions with beneficial and pathogenic microbes
|
![]()  Sarah Shehata Sarah Shehata
Affiliate
About Me Post-Northen Lab:
Scientist at Abbott
Research in Northen Lab:
Utilizing MZmine and QIIME
|
![]()  Gursachi Sikka Gursachi Sikka
Student Assistant
About Me Post-Northen Lab:
Research in Northen Lab:
|
![]()  Leslie Silva Leslie Silva
Staff
About Me Post-Northen Lab:
Director of Analytical Chemistry at Ava Winery
Research in Northen Lab:
Understanding microbial metabolism can help us understand soil metabolites and how microbes live in communities (JGI Metabolomics User Program)
|
![]()  Anita Silver Anita Silver
Research Intern
About Me Post-Northen Lab:
PhD Candidate at Duke BME
Research in Northen Lab:
Quantifying interactions between microbes using exometabolomic data
|
![]()  Kriti Sondhi Kriti Sondhi
Student Assistant
About Me Post-Northen Lab:
Research in Northen Lab:
|
![]()  David Sonojo David Sonojo
Student Assistant
About Me Post-Northen Lab:
Research in Northen Lab:
|
![]()  Tami Swenson Tami Swenson
Scientific Engineering Associate
About Me Post-Northen Lab:
Study Director at Labcorp Drug Development
Research in Northen Lab:
Microbial nutrient cycling in soil
|
![]()  Jane Tanamachi Jane Tanamachi
Administrative Assistant
About Me Post-Northen Lab:
Program Manager at Lawrence Berkeley National Labs
|
![]()  Catriona Thompson Catriona Thompson
Affiliate Postdoc Visitor
Email |
![]()  Connor Tomaka Connor Tomaka
Research Associate
About Me Post-Northen Lab:
Computational Microbiome Researcher at University of California, San Francisco
|
![]()  Daniel Treen Daniel Treen
Research Assistant
About Me Post-Northen Lab:
Data Scientist at Enveda Biosciences
Research in Northen Lab:
Custom Metabolomics Analysis Tools
|
![]()  Marc Van Goethem Marc Van Goethem
Postdoctoral Researcher
About Me Post-Northen Lab:
Postdoctoral Researcher at KAUST (King Abdullah University of Science and Technology)
Research in Northen Lab:
Linking metagenomics and metabolomics in soil biocrust
|
![]()  Tim Veth Tim Veth
Student Assistant
About Me Post-Northen Lab:
Master’s Student at Utrecht University
|
![]()  Michelle van Winden Michelle van Winden
Student Assistant
About Me Post-Northen Lab:
Plant Science Master’s Student at Wageningen University & Research
|
![]()  Hayden Veytia Hayden Veytia
Student Assistant
About Me Post-Northen Lab:
Graduate Student at Reed College
|
![]()  Forrest Vogel Forrest Vogel
Student Assistant
About Me Post-Northen Lab:
Loyola Marymount University
Research in Northen Lab:
Building fabricated ecosystems
|
![]()  Hunter Vogel Hunter Vogel
Student Assistant
Email |
![]()  Michael Vu Michael Vu
Research Assistant
LinkedIn Email |
![]()  LinLin Wang LinLin Wang
Affiliate
About Me Post-Northen Lab:
Graduate student from Jinan University
Research in Northen Lab:
Molecular recognition and interaction between triphenyltin and amino acids, inactive proteins, and active proteins of Bacillus thuringiensis.
|
![]()  Benjamin Walker-Edwards Benjamin Walker-Edwards
Student Assistant
About Me Post-Northen Lab:
University of Berkeley Undergraduate Student
Research in Northen Lab:
|
![]()  Ying Wang Ying Wang
Post-Doctoral Researcher
About Me Post-Northen Lab:
Assistant Professor at Texas A&M University
Research in Northen Lab:
Research soil microbiomes using synthetic ecology, metabolomics, proteomics, isotope, and modeling
|
![]()  Katherine Whiting Katherine Whiting
Student Assistant
About Me Post-Northen Lab:
University of Edinburgh, Master’s degree program in neuroscience
Research in Northen Lab:
|
![]()  Jordan Wilson Jordan Wilson
Undergraduate Student Assistant
LinkedIn Email |
![]()  Edi Wipf Edi Wipf
Post-Doctoral Researcher
About Me Post-Northen Lab:
Postdoctoral Scholar, Environmental Genomics and Systems Biology Division at Berkeley Lab
Research in Northen Lab:
Characterizing the role of drought and heat stress, plant domestication, agricultural soil management practices, and host genome duplication on microbiome assembly of several different crop plants.
|
![]()  Jinshao Ye Jinshao Ye
Visiting Professor
About Me
Research in Northen Lab:
The role of microbes in bioremediation processes
|
![]()  Bin Yoo Bin Yoo
Student Assistant
About Me Post-Northen Lab:
Research in Northen Lab:
|
![]()  Matt Youngblood Matt Youngblood
Student Assistant
About Me Post-Northen Lab:
Research in Northen Lab:
|
![]()  Kateryna Zhalnina Kateryna Zhalnina
Scientist, Berkeley Lab
About Me Post-Northen Lab:
Research Scientist at Berkeley Lab
Research in Northen Lab:
The role of microorganisms in the rhizosphere priming of soil organic matter decomposition
|
![]()  Qing Zheng Qing Zheng
Post-Doctoral Researcher
About Me Post-Northen Lab:
Project Scientist at UC Davis
Research in Northen Lab:
Host-microbe interactions in biocrusts
|